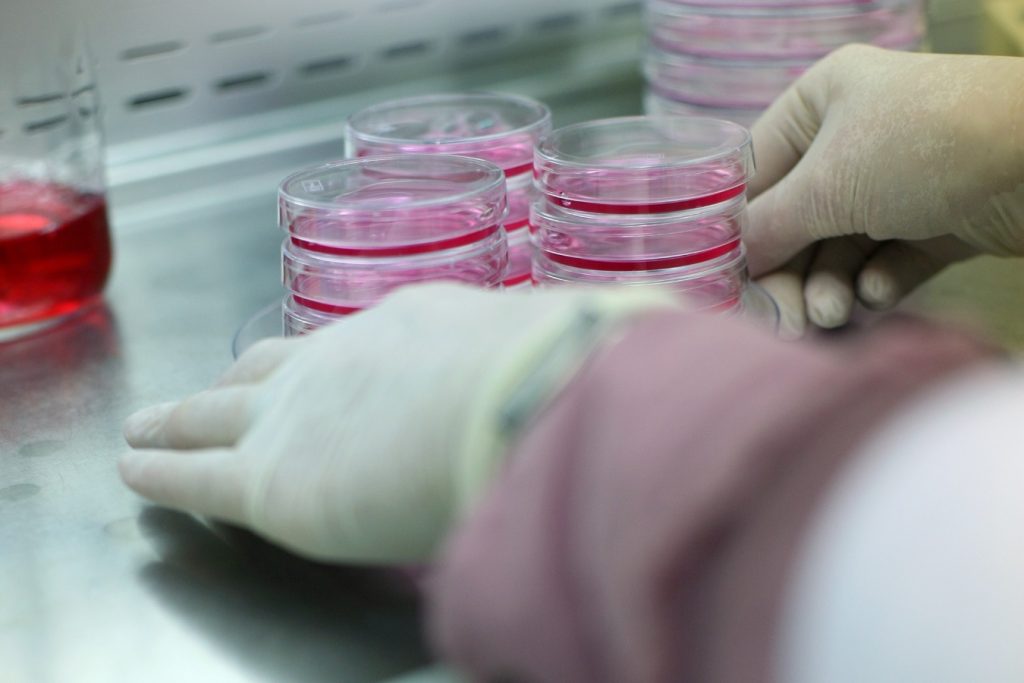

Acasă » Interviuri » Interviu Prof. Marieta Costache
Interviu Prof. Marieta Costache

Prof. Marieta Costache a absolvit Facultatea de Biologie, Secția Biochimie. Încă din primul an de facultate și-a dorit să devină cadru didactic al Catedrei de Biochimie, dar la finalizarea studiilor a fost repartizată la Fabrica de Celuloză și Hârtie de pe platforma industrială a combinatului chimic de la Brăila, urmată de dubla repartiție la Institutul Pasteur București și Institutul de Biochimie al Academiei Române. Visul de a reveni la facultate i s-a împlinit abia în 1990, cand a obținut prin concurs un post de asistent la Catedra de Biochimie, Facultatea de Biologie, Universitatea din București. Șansa carierei științifice a fost un program TEMPUS coordonat de dr. Rita Barot de la Universitatea Paris XI și prof. dr. Dana Iordăchescu, de la Catedra de Biochimie.
Sunteți profesor, dar și cercetător. Care dintre aceste două activități vi se potrivește cel mai bine?
Cred că pentru mine aceste două profesii merg mână-n mână. Sunt profesor și formator și nu m-aș putea desprinde de interacțiunea cu studenții mei. Consider că cel mai bine mi se potrivește rolul de dascăl, de profesor. Predau biologia moleculară studenților de la Secția de Biochimie, dar și genomica și transcriptomica și bazele moleculare ale maladiilor studenților de la Masterul de Biochimie și Biologie Moleculară și fac acest lucru cu multă pasiune și placere. Cu toate acestea, nu aș putea afirma că activitatea de cercetare este pe plan secundar, pentru că noi, dascalii, nu putem fi cu adevărat formatori fără să fim mereu în pas cu ultimele abordări ale științei. Nu ar fi posibil să transmit pasiunea mea pentru aceste discipline studenților, decât dacă le aduc și exemple, dacă le pot face legătura cu aplicația și cu punerea în practică a acestor noțiuni.
Spuneați că cercetarea este a doua dimensiune, fără de care nu putem exista. Cum ați defini un colectiv de cercetare eficient?
Da, este adevărat, spuneam asta într-un alt interviu. Cercetarea trebuie făcută cu pasiune, abnegație, tenacitate și cu multe, multe sacrificii. Înainte să încerc să definesc un colectiv de cercetare eficient, aș dori să vă spun cât de importante sunt colectivele de cercetare din institute și universități. Este greu să pui bazele unui colectiv de cercetare, dar cel mai greu, în România de astăzi, este să păstrezi și să dezvolți acel colectiv de cercetare. Resursa umană tânără este ceea ce lipsește majorității institutelor și universităților. Un colectiv de cercetare trebuie să fie, în primul rând, unit. Nu este ușor să fii cercetător în ziua de azi, fondurile sunt foarte mici și trăiești tot timpul sub presiunea de a obține un nou grant și o modalitate de a-ți finanța cercetările și grupul. Un colectiv de cercetare trebuie să funcționeze ca rotițele unui mecanism, fiecare membru trebuie să fie expert în aria lui de cercetare, dar ideile să se întrepătrundă și să funcționeze în același sens. Eficiența cu care funcționează un grup în cercetare este dată de calitatea membrilor săi. Cu cât ai cercetători cât mai competenți, entuziaști, perseverenți și motivați lângă tine, cu atât ideile se conturează mai bine, discuțiile sunt mai constructive și experimentele mai inovative. În cercetare se înaintează cu pași mici, dar siguri.
Care sunt noile direcții de cercetare pe plan național?
În ultimii ani, cercetarea din România a investit foarte mult în dezvoltarea laserului de la Măgurele și sunt convinsă că proiectul acesta va deschide noi direcții de cercetare în România și noi colaborări. Mai aproape de domeniul meu de activitate, cred că celule stem și aplicațiile lor pentru medicină vor avea în continuare căutare și interes pentru cercetători. Mecanismele prin care aceste celule pot fi diferențiate în alte tipuri celulare și versatilitatea lor nu sunt încă pe deplin explorate. Tot mai multă amploare ia în ultima vreme utilizarea celulelor stem pluripotent-induse (iPSC), care oferă practic cercetătorului posibilitatea de a studia căile și mecanismele de dezvoltare embrionară și modele de patogeneză fără a utiliza embrioni, atât de controversați din punct de vedere etic. În biologia moleculară în România, tendința este cea de aliniere la direcțiile de studiu din străinătate. Se pune accent din ce în ce mai mult pe aprofundarea mecanismelor epigenetice, celor de control post-transcripțional sau pe studiul microveziculelor cu rol de transportor de semnale moleculare. Nu în ultimul rând, domeniul farmaceutic, farmacogenomic și terapia țintită în cancer, diabet și boli cardiovasculare ocupă un loc important în cercetarea actuală. În grupul de cercetare pe care îl conduc abordăm problema medicinei regenerative din perspectiva studierii interacțiunilor dintre celulele stem și biomateriale implantabile. Aceste studii vizează reconstrucția țesuturilor moi, regenerarea cartilajului și a țesutului osos, precum și îmbunătățirea procesului de vindecare al plăgilor în cazul pacienților cu maladii cronice, cum ar fi diabetul sau neoplasmele.
Fiecare organ este „dotat” cu o „armată” de celule stem. Ce înseamnă asta pentru medicina regenerativă?
Cercetarile din ultimii ani au evidențiat, într-adevăr, populații distincte de celule nediferențiate, situate în nișe aproape la nivelul fiecărui organ. Cu alte cuvinte, fiecare organ dispune ipotetic de o rezervă de celule stem care poate fi activată în cazul unei leziuni la nivelul organului respectiv. Această descoperire a revoluționat medicina regenerativă atunci când cercetătorii au înțeles potențialul imens al unui astfel de rezervor și capacitatea de autoreparare cu care organismul uman a fost înzestrat. Cei care activăm în acest domeniu de cercetare am dus studiile mai departe și am înțeles că dacă mobilizăm controlat aceste rezerve la locul leziunii și ajutăm prin adăugarea unui implant adecvat și a semnalelor necesare, putem obține regenerarea cu succes a unui țesut.
Ați fi putut rămâne să profesați în Franța, cu toate acestea ați ales să vă întoarceți în România. Regretați ceva?
Da, aș fi putut rămâne în Franța și nu am făcut-o pentru că am avut dorința și convingerea că pot construi ceva la mine acasă. Fără sa fiu lipsită de modestie, pot spune că am dorința și disponibilitatea de a construi. Din acest motiv m-am întors acasă și dacă mă uit în urmă la ultimii 20 de ani, cred că am reușit câte ceva: primul laborator de biologie moleculară de la Universitatea din București, primele cursuri de biologie moleculară de la specializarea de licență biochimie și primele cursuri de genomică și transcriptomică și patologie moleculară de la masterul de biochimie și biologie moleculară, platforma de cercetare în biologie și ecologie sistemică.
Povestiți-ne puțin despre tema abordată anul acesta în cadrul congresului SIMCR, vă rugăm.
Anul aceasta la congresul de medicină regenerativă SIMCR abordăm două teme interesante, susținute de două colege tinere din grupul meu de cercetare (CS III Dr. Sorina Dinescu și CS III Dr. Bianca Gălățeanu). Acestea vor prezenta două biomateriale diferite și două abordări noi de interes pentru medicii care activează în domeniul ingineriei tisulare și medicinei regenerative: i) terapia cu celule stem și biomateriale în vederea regenerării osoase care vizează utilizarea de plasmă bogată în plachete sangvine ca terapie adjuvantă în procesul regenerativ; ii) potențialul utilizării câmpului magnetic static pentru stimularea celulelor stem adulte aflate în structuri 3D naturale, biocompatibile. Această aplicație își poate găsi utilitatea în vindecarea plăgilor cronice la pacienții cu diabet sau în repararea fracturilor osoase, deoarece câmpul magnetic stimulează in vitro atât proliferarea celulelor stem, cât și programul lor de diferențiere.
Deține România tehnologia necesară în cercetare?
În România, infrastructura pentru cercetare a evoluat mult în ultimii ani. Da, România are tehnologia necesară abordării unor domenii de vârf. S-au facut eforturi în ultimii 20 de ani pentru a construi noi platforme și institute de cercetare dotate cu aparatură modernă, de ultimă generație, la standarde europene. Multe institute de cercetare și universități au beneficiat de fonduri pentru dezvoltare și dotarea laboratoarelor. Și noi, în cadrul Universității din București am obținut finanțare din fonduri europene pentru construcția și dotarea unei platforme de cercetare de nivel internațional, precum și pentru modernizarea și extinderea unor stațiuni de cercetare ale Facultății de Biologie (de la Sinaia și Brăila). Asa a apărut Platforma de Cercetare în Biologie și Ecologie Sistemică (PCBE), dotată cu tehnologii de ultimă generație pentru analize de biologie moleculară, biochimie, biologie celulară, neurobiologie, ecologie, microbiologie și genetică, unde activează în prezent cercetători seniori, postdoctoranzi și doctoranzi. Problema noastră, a tuturor, este resursa umană performantă tânără. Nu am putut și nu putem să ne ținem tinerii acasă din cauza slabei finanțări pentru funcționarea cercetării.
Sunteți implicată în vreun proiect de cercetare în acest moment? Dacă da, ne puteți spune mai multe?
Alături de colegii din colectivul din care fac parte și cu cei din departamenul de biochimie și biologie moleculară de la Facultate de Biologie, Universitatea din București, derulăm mai multe proiecte de cercetare în diferite direcții. În cariera mea de cercetător, am contribuit la dezvoltarea biologiei moleculare în România și am dezvoltat o nouă direcție de cercetare prin evaluarea de markeri moleculari la animale crescute în ferme. În ultimii ani, derivat din această direcție, am avansat cu cercetările referitoare la sturioni, specii cu uriașă importantă economică. În ceea ce privește direcția medicinei regenerative dezvoltată în ultimii ani, avem în desfășurare un proiect de cercetare care vizează evaluarea efectului plasmei bogate în plachete sangvine și optimizarea utilizării acesteia pentru procese regenerative. De asemenea, avem un proiect de cercetare care își propune identificarea unei noi metode de detecție a celulelor tumorale circulante.
Ce probleme credeți că va putea rezolva medicina regenerativă în următorii ani?
Având în vedere numărul mare de studii in vitro și in vivo care se fac în prezent în domeniul medicinei regenerative, perspectivele de viitor ar putea fi foarte optimiste. Medicina regenerativă intervine deja într-un mod pozitiv în viețile pacienților care suferă de diverse defecte sau leziuni tisulare. În prezent, cea mai eficientă abordare este terapia cu celule stem asistată. Trendul actual este cel de producere de organoizi, structuri care recapitulează in vitro complexitatea organelor sau țesuturilor, această direcție având ca scop în viitor producerea de țesuturi în laborator pentru utilizare în medicina regenerativă. Există o varietate atât de mare de patologii abordate cu succes în laborator până în prezent, încât nu le-aș putea enumera acum pe toate. Cred că optimizarea acestor metode practicate în prezent în laborator va conduce la îmbunătățirea terapiilor care se adresează principalelor patologii – cancere, diabet, boli cardiovasculare, precum și la refacerea eficientă a țesuturilor. Medicina regenerativă evoluează cu pași repezi și, împreună cu chirurgia estetică și reparatorie, vor contribui semnificativ la îmbunătățirea vieții pacienților.
Cuvinte-cheie: catedra de biochimie, institutul nicolae simionescu, interviu marieta costache, marieta costache
Fii conectat la noutățile și descoperirile din domeniul medico-farmaceutic!
Utilizam datele tale in scopul corespondentei si pentru comunicari comerciale. Pentru a citi mai multe informatii apasa aici.